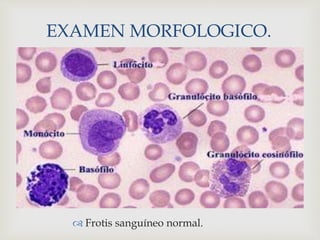

EXAMEN MORFOLOGICO.
 Frotis sanguíneo normal.

El documento resume las características de la leucemia linfoblástica aguda (LLA). La LLA es una enfermedad neoplásica que se origina de la mutación somática de un progenitor linfoide único. Se caracteriza por la proliferación anormal de linfocitos en la médula ósea que causa supresión de la hematopoyesis normal. Su diagnóstico requiere exámenes morfológicos, inmunofenotípicos y citogenéticos. Su tratamiento incluye quimioterapia con agentes como met

![
ESTUDIO
CITOGENÉTICO.
Anormalidad mas común: cromosoma Filadelfia (Ph)
[t(9;22)] translocación que provoca la fusión de los genes
BCR-ABL relacionada cerca del 20% con la LLA adulto
y 5% en niños.
Translocación mas frecuente en niños con LLA es
t(12;21) con los genes TEL-AML1. 25% LLA niñez y LLA
adulto.
Elaboro: López Luis Daniel; Nava Raúl.
Referencias: : Goldmann & Bennett: Cecil Tratado de Medicina Interna, 21 ED. VOL 1; LEUCEMIAS AGUDAS; pág..
1055-1056.](https://image.slidesharecdn.com/lla-151019043250-lva1-app6892/85/Leucemia-linfoblastica-aguda-23-320.jpg)















![EXAMENES DE LABORATORIO.
PARÁMETROS VALORES DE REFERENCIA
ERITROCITOS (RBC) 4.00 – 6.20 [10^6/uL]
HEMOGLOBINA (HGB) 11 - 18 [g/dL]
HEMATOCRITO (HCT) 35.0 – 55.0 [%]
VCM 80.0 - 100 [fL]
HCM 26 - 34 [pg]
CHCM 31 - 36 [g/dL]
RDW 30.0 – 50.0 [fL]
PLAQUETAS (PLT) 150 - 450 [10^3/uL]
LEUCOCITOS (WBC) 4.5 – 10.0 [10^3/uL]
NEUTROFILOS 2.0 – 3.0 [10^3/uL]
LINFOCITOS 0.8 – 5.1 [10^3/uL]
MONOCITOS 0.1 – 1.0 [10^3/uL]
EOSINOFILOS 0 – 0.5 [10^3/uL]
BASOFILOS 0.2 – 1.0 [10^3/uL]
TABLA. 1.1 BIOMETRÍA HEMÁTICA COMPLETA (PARÁMETROS NORMALES).](https://image.slidesharecdn.com/lla-151019043250-lva1-app6892/85/Leucemia-linfoblastica-aguda-39-320.jpg)
![Elaboro: López Luis Daniel; Nava Sánchez Raul.
Fuente: Archivo clínico.
PARÁMETROS. BH.
8/03/13
BH.
15/04/13
BH.
6/08/13
VALORES DE
REFERENCIA
WBC 11.7 11.3 21.35 4.5 – 10.0
[10^3/uL]
RBC 3.77 3.70 2.95 4.00 – 6.20
[10^6/uL]
HGB 12.5 11.6 9.3 11 - 18 [g/dL]
HCT 35 34.3 28 35.0 – 55.0 [%]
PLT 197 101 132 150 - 450
[10^3/uL]
TABLA 1.2 BIOMETRÍA HEMÁTICA (COMPARACIÓN CRONOLOGICA).](https://image.slidesharecdn.com/lla-151019043250-lva1-app6892/85/Leucemia-linfoblastica-aguda-40-320.jpg)
![PARÁMETROS. BH.
20/08/13
BH.
23/08/13
BH.
1/09/13
VALORES DE
REFERENCIA.
WBC 41.69 18.73 43.93 4.5 – 10.0
[10^3/uL]
RBC 1.6 2.51 2.90 4.00 – 6.20
[10^6/uL]
HGB 4.9 7.6 8.4 11 - 18 [g/dL]
HCT 13.9 23.2 26.3 35.0 – 55.0 [%]
PLT 30 20 7 150 - 450
[10^3/uL]
Elaboro: López Luis Daniel; Nava Sánchez Raul.
Fuente: Archivo clinico.
TABLA 1.3 BIOMETRÍA HEMÁTICA (COMPARACIÓN CRONOLOGICA).](https://image.slidesharecdn.com/lla-151019043250-lva1-app6892/85/Leucemia-linfoblastica-aguda-41-320.jpg)




